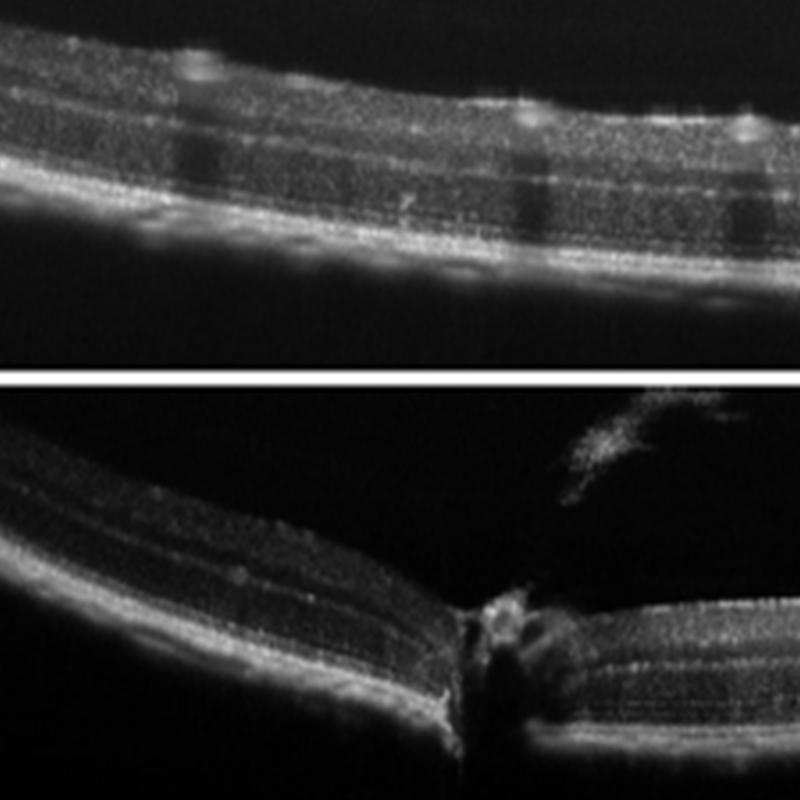

スペック
スペクトルドメインOCT用分光器 Cobra

| 製品シリーズ | 選択可能波長帯(帯域幅) | 特徴 | アプリケーション |
| Cobra VIS | 400-700 nm (80-200 nm) |
高分解能、血中酸素マッピング
|
血管造影、3D血中酸素マッピング、網膜イメージング、3D顕微鏡検査
|
| Cobra-S 800 | 650-950 nm (28-300 nm) | 高速、高分解能 |
網膜及び前眼房イメージング、血管造影、振動計、リアルタイムイメージング、原料検査
|
| Cobra-D 800 | 800-880 nm (28-80 nm) | 深さ、産業対応 | ロングレンジイメージング、眼科、薬品、産業プロセスモニタリング |
| Cobra 1050 | 1000-1110 nm (110 nm) | 汎用性が高い |
脈絡膜イメージング、網膜血管系レーザー凝固治療
|
| Cobra 1300 | 950-1690 nm (73-500 nm) | 深度優先 |
皮膚科、眼球前部イメージング、表面下材質検査
|
| Cobra 1600 | 1450-1690 nm (240 nm) |
高スキャッタリングサンプル
|
光干渉顕微鏡、血管内OCT、非破壊検査 |
| Cobra OEM | 750-930 nm (90-180 nm) | 小型軽量 | OEM組込み、材料加工、検査、眼科 |
-
高分解能可視領域モデル
Cobra VIS OCT Spectrometer
-
ハイスピード高分解能モデル
Cobra-S 800 OCT Spectrometer
-
産業対応ロングレンジイメージング
Cobra-D 800 OCT Spectrometer
-
分解能・深度バランスモデル
Cobra 1050 OCT Spectrometer
-
深度優先モデル
Cobra 1300 OCT Spectrometer
-
高スキャッタリングサンプルにも
Cobra 1600 OCT Spectrometer
-
小型軽量OEMタイプ
Cobra OEM OCT Spectrometer
アプリケーション
研究・解析用途: 生体系・バイオ系イメージ (WP OCTシリーズ)
-

人体・指 (爪と甘皮)
-

玉ねぎの細胞
-

葉脈
品質保証・非破壊検査用途: 産業用製品・サンプル薄膜、内部イメージ (WP OCTシリーズ)
-

粘着テープ断面
-

ソフトコンタクトレンズ・エッジ部
-

可食医療カプセル複合部
-

車ボディ塗装膜厚さ・くぼみ断面
-

ゴリラガラス厚さ・内部断面
研究・解析用途: 生体眼内部イメージ (動物用測定プローブ使用)
-
網膜断層
-

ねずみ全眼断層
研究・解析用途: 生体毛細血管内部イメージ (WP MicroAngio)
-

心臓毛細血管画像
-

網膜血管系
-

ねずみ網細血管